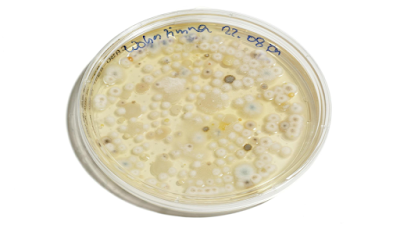

Inhibidores de la liberación de mediadores
Su mecanismo de acción no es muy bien conocido, aunque se cree que actúan inhibiendo la liberación de sustancias mediadoras de la inflamación del árbol bronquial.
El Cromoglicato disódico y Nedocromilo se administran por inhalación, no se absorben por vía oral. Ambos apenas tienen efectos secundarios.
Su mecanismo de acción no es muy bien conocido, aunque se cree que actúan inhibiendo la liberación de sustancias mediadoras de la inflamación del árbol bronquial.
El Cromoglicato disódico y Nedocromilo se administran por inhalación, no se absorben por vía oral. Ambos apenas tienen efectos secundarios.